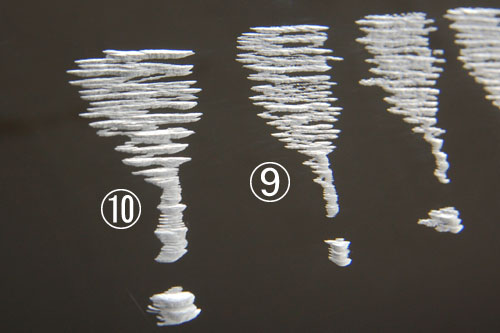

皆様、こんにちは。
アクリ屋ブログ新製品レポート担当です。
毎日いかがお過ごしでしょうか。
今回の新製品レポートは、先日ご紹介した「ミニコング2キット」の2回目になります。
前回の記事は「ミニコング2キット付属のビットをご紹介」で確認できますので、今回の記事の前に是非ご一読下さい。
早速ですが、付属ビットの中からアクリルDIYに活用できるビットの削り具合を、実際にアクリル板を削ってご紹介致します。
先ずは切削ビットの「ロータリーやすり」から。
※全てアクリル板の表側から加工

※この写真のみアクリル板の裏側から見た状態
写真ではちょっと分かり難いですが、ビットの先端の形状が違うだけで、加工跡がかなり違っているのがお分かり頂けるかと思います。
また、切削用と言うだけの事はあってアクリル板に凹みが出来ていますし、爪でなぞるとカタカタと引っ掛かります。
特に7・8・9・10番のビットは比較的深く掘ることが出来ます。
5枚目の写真で深さのイメージが少しでも伝われば良いのですが・・・
ただ、これらのビットは削る力が強い為に回転速度を上げる必要がありますし、その分押さえる力も必要になりますので、作業をする時には充分注意して下さい。
次に「ダイヤモンドバー」。




これらのビットも先端の形状によって削り具合が異なっているのが分かるかと思います。
切削用ビットとは違い、アクリル板の表面に傷を付けているだけで、爪が引っ掛かる程の凹みはありません。
表面がザラザラになっている程度です。
「ロータリーやすり」と比べると削る際に板に引っ掛かる感じはなく、比較的使い勝手は良いのではないでしょうか。
ただ、先端が細い2番と6番は使う時にちょっと工夫が必要になると思います。
個人的には1番のビットの使い勝手が良かったです。
加工する物や加工面積など、その時の状況に合わせて使い分けてみて下さい。
次に「真鍮ブラシホイール型(ゴールド)」と「鉄波ブラシホイール型(シルバー)」。
前回の記事でアクリルには適していないとご紹介しましたが、実際にどうなるのかご紹介。

左が鉄波ブラシホイール型でアクリル板の表面を荒らした跡で、右が真鍮ブラシホイール型で荒らした跡になります。
ご覧の通り表面がかなり荒れています。
特に鉄波ブラシホイール型は表面が溶けているようにも見えます。
これらのブラシをアクリルに使うことはないかと思いますが、あくまでも参考程度に、と言う事で。
いかがでしたでしょうか。
今回はアクリルDIYに便利なビット(+おまけ)を少しだけ掘り下げてご紹介致しました。
削った際のイメージが少しでも伝われば嬉しく思います。
次回は、実際にダイヤモンドバーを使用して、アクリルパイプに彫刻をしてみたいと思います。
さて、うまく彫刻できるのでしょうか・・・
私個人の趣味で切削用ビットを使用してレジンの固まりを削る事はあるのですが、ダイヤモンドバーを使って彫刻するのは初めてなので、実はかなり不安です。
今回の新製品レポートはここまで。
それでは素敵な1日を。
使用製品:ミニコング2キット
前回の記事:ミニコング2キット付属のビットをご紹介








